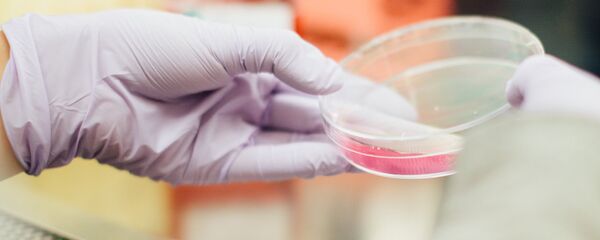
Un laboratorio (imagen referencial) - Sputnik Mundo

El legislador presentó en julio una enmienda a la Ley de Autorización de la Defensa Nacional de 2020 para que el inspector general del Pentágono revisara si el Departamento de Defensa realizó unas pruebas con insectos entre los años 1950 y 1975.
Y si esta hipótesis es cierta, Smith considera importante averiguar qué tipo de experimentos se llevaron a cabo, qué propósito tenían y si las garrapatas o algunos insectos habían sido liberados al entorno accidentalmente o como parte del experimento, lo que podría haber causado la propagación de distintas enfermedades, incluida la de Lyme, en el país.
'Insectos aliados': ¿nuevo programa de armas biológicas del Pentágono? https://t.co/6MB4foNvzP pic.twitter.com/NyjQ2uBVv1
— Sputnik Mundo (@SputnikMundo) October 8, 2018
El congresista hace referencia al libro de Kris Newby Historia de la enfermedad de Lyme y las armas biológicas que incluye entrevistas con Willy Burgdorfer, a quien se le atribuye haber descubierto el patógeno que causa la enfermedad de Lyme y supuestamente haber desarrollado armas biológicas para el Departamento de Defensa.
"Esas entrevistas combinadas con el acceso a los archivos de laboratorio del Dr. Burdorfer sugieren que él y otros especialistas en armas biológicas infectaron las garrapatas con patógenos para causar discapacidades severas, enfermedades e incluso muerte a los enemigos potenciales", afirmó Smith.
"Con la enfermedad de Lyme y otras enfermedades transmitidas por garrapatas que se propagan por Estados Unidos, los estadounidenses tienen derecho a saber si algo de esto es verdad", citaron los medios al congresista.
Según el exmicrobiólogo militar, coronel de reserva Mijaíl Supotnitski, consultado por el diario ruso Komsomolskaya Pravda (KP) nunca ha sido secreto que en EEUU se trabajaba y se sigue trabajando en la creación de las armas biológicas.
No obstante, el experto observó que aunque la idea de usar insectos para propagar enfermedades peligrosas pareciera muy simple, en realidad es muy difícil de llevar a la práctica.
"Es difícil criar, infectar y mantener a los insectos en un estado infectado durante mucho tiempo. El principal inconveniente de utilizarlos para una guerra biológica es que mueren en masa durante la entrega al objetivo".
El militar recordó que en 1954 los estadounidenses probaron bombas con pulgas no infectadas para evaluar su capacidad de supervivencia. Se colocaron unas jaulas con conejillos de indias en el suelo. Un avión de guerra lanzó bombas con 670.000 pulgas. Los militares solo encontraron 177 pulgas en los conejillos. Faltaban los 669.823 restantes.
"Lo más probable es que la mayoría muriera durante el vuelo. También necesitan respirar. Una de las bombas era defectuosa, las pulgas picaron a los tripulantes", contó Supotnitski.
Según el microbiólogo, el comportamiento de las garrapatas, pulgas y mosquitos infectados entregados al objetivo es imposible de controlar ni prever. Pueden no infectar a nadie, sino morir de la infección, mientras que cada insecto cuesta bastante dinero.
El militar explicó que no son insectos, sino el uso de aerosoles la forma más eficaz de propagar los agentes biológicos.
Pero entonces, ¿qué provocó un brote de la enfermedad de Lyme en EEUU? Según Supotnitski, los protagonistas en esta historia son los ciervos porque con ellos se alimentan las garrapatas Ixodes. El microbiólogo observó que Connecticut y sus estados vecinos, donde fue descubierta en 1975 por Willy Burgdorfer y todavía se basa la enfermedad de Lyme, están en la costa este. A principios del siglo XIX, los colonos talaron grandes cantidades de árboles para desarrollar la agricultura allí. Con la destrucción de los bosques, la población de ciervos ha disminuido significativamente.
Sin embargo, a mediados del siglo XIX, la agricultura estadounidense comenzó a desplazarse rápidamente hacia el oeste, y las granjas locales fueron abandonadas. El este de EEUU volvió a cubrirse de árboles, pero era un bosque ralo sin suficientes depredadores para regular las poblaciones de ciervos. Estos animales comenzaron a reproducirse rápidamente. Junto con ellos, empezaron a propagarse las garrapatas.
Al picar a un ser humano, la garrapata de ciervo lo infecta con la espiroqueta que causa la enfermedad de Lyme, explicó Supotnitski y agregó que fue la proximidad de humanos, ciervos y garrapatas lo que causó un brote de la enfermedad de Lyme.
"Así que la generación actual de estadounidenses simplemente está pagando por los pecados de sus bisabuelos, y nada más. La espiroqueta Borrelia burgdorferi vivía en EEUU mucho antes de ser descubierta por el microbiólogo militar Willy Burgdorfer", señaló el militar ruso.
Supotnitski enfatizó que cuando entramos en contacto con el mundo de los microorganismos, a menudo ni siquiera nos damos cuenta de que este mundo tiene miles de millones de años. "Somos nosotros quienes vivimos en su territorio y en su historia, y no al revés".
"Es necesario buscar las razones de su reproducción e infección en las cambiantes condiciones ambientales, como en el calentamiento del clima, que ha provocado cambios globales en los ecosistemas que incluyen garrapatas y microorganismos que parasitan en ellos", concluyó el experto.